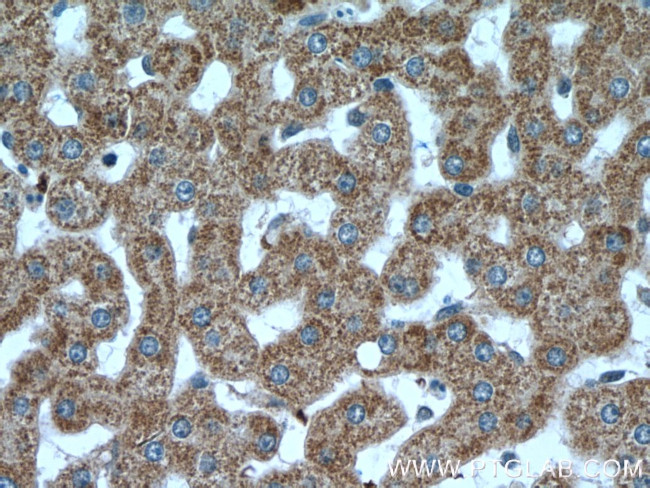
VPS41 Antibody in Immunohistochemistry (Paraffin) (IHC (P))

Search
Proteintech
VPS41 Polyclonal Antibody
{{$productOrderCtrl.translations['antibody.pdp.commerceCard.promotion.promotions']}}
{{$productOrderCtrl.translations['antibody.pdp.commerceCard.promotion.viewpromo']}}
{{$productOrderCtrl.translations['antibody.pdp.commerceCard.promotion.promocode']}}: {{promo.promoCode}} {{promo.promoTitle}} {{promo.promoDescription}}. {{$productOrderCtrl.translations['antibody.pdp.commerceCard.promotion.learnmore']}}
产品信息
13869-1-AP
种属反应
已发表种属
宿主/亚型
分类
类型
抗原
偶联物
形式
浓度
规格
纯化类型
保存液
内含物
保存条件
运输条件
产品详细信息
Immunogen sequence: DSQNKTLLK TLAELYTYDK NYGNALEIYL TLRHKDVFQL IHKHNLFSSI KDKIVLLMDF DSEKAVDMLL DNEDKISIKK VVEELEDRPE LQHVYLHKLF KRDHHKGQRY HEKQISLYAE YDRPNLLPFL RDSTHCPLEK ALEICQQRNF VEETVYLLSR MGNSRSALKM IMEELHDVDK AIEFAKEQDD GELWEDLILY SIDKPPFITG LLNNIGTHVD PILLIHRIKE GMEIPNLRDS LVKILQDYNL QILLREGCKK ILVADSLSLL KKMHRTQMKG VLVDEENICE SCLSPILPSD AAKPFSVVVF HCRHMFHKEC LPMPSMNSAA QFCNICSAKN RGPGSAILEM KK (504-854 aa encoded by BC044851)
靶标信息
Vesicle mediated protein sorting plays an important role in segregation of intracellular molecules into distinct organelles. Genetic studies in yeast have identified more than 40 vacuolar protein sorting (VPS) genes involved in vesicle transport to vacuoles. This gene encodes the human ortholog of yeast Vps41 protein which is also conserved in Drosophila, tomato, and Arabidopsis. Expression studies in yeast and human indicate that this protein may be involved in the formation and fusion of transport vesicles from the Golgi. Several transcript variants encoding different isoforms have been described for this gene, however, the full-length nature of not all is known.
仅用于科研。不用于诊断过程。未经明确授权不得转售。
生物信息学
蛋白别名: mVAM2; S53; unnamed protein product; vacuolar assembly protein 41; vacuolar protein sorting 41 homolog; Vacuolar protein sorting-associated protein 41 homolog; VAM2 homolog; VPS41, HOPS complex subunit
基因别名: AI317346; HVPS41; hVps41p; HVSP41; mVam2; SCAR29; Vam2; VPS41
UniProt ID: (Human) P49754, (Mouse) Q5KU39
Entrez Gene ID: (Human) 27072, (Mouse) 218035